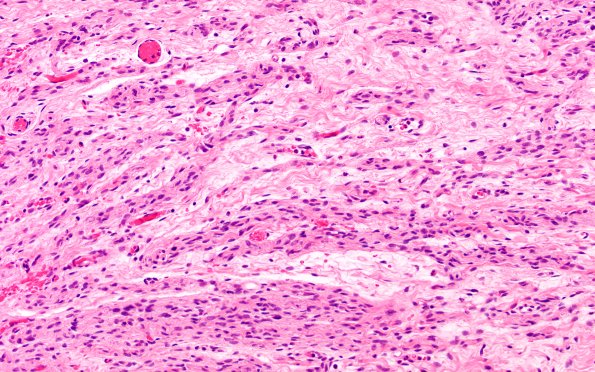
14A2 Neuroma, traumatic (Case 14) H&E near DRG 20X 1

Table of Contents
Washington University Experience | PERIPHERAL NEUROPATHY | 19 TRAUMATIC INJURIES | 14A2 Neuroma, traumatic (Case 14) H&E near DRG 20X 1
14A2,3 Higher magnification of the mini-fascicle (14A2) and haphazard collections of regenerating axons (14A3). (H&E)